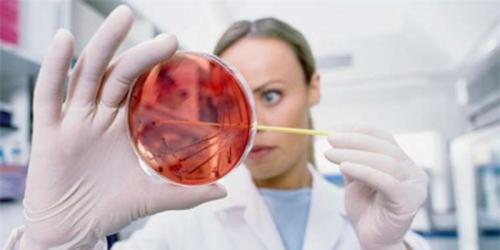
与死神对抗:公共卫生专业大揭秘 与死神对抗:公共卫生专业大揭秘

公共卫生是关系到一个国家或者一个地区人民大众健康的公共事业,涉及内容广泛,从对重大疾病尤其是传染病(如结核、、SARS等)的预防、监控和医治,到对食品、药品、公共环境卫生的监督管制,再到相关的卫生宣传、健康教育及免疫接种,都是公共卫生的具体工作对象。那么,英国的公共卫生专业是怎样的呢?英国公共卫生专业优秀院校又有哪些呢?
1,伦敦大学学院 ucl
专业:Health and Society: Social Epidemiology MSc健康与社会:社会流行病学
2,帝国理工学院 ic
专业:Master of Public Health (MPH)公共卫生
3,伦敦大学国王学院kcl
专业:Public Health MPH公共卫生
4,爱丁堡大学 Edinburgh
专业:Public Health MPH公共卫生
5,布里斯托大学 Bristol
专业:MSc Public Health公共卫生
6,格拉斯哥大学 Glasgow
专业:PUBLIC HEALTH MPH 公共卫生